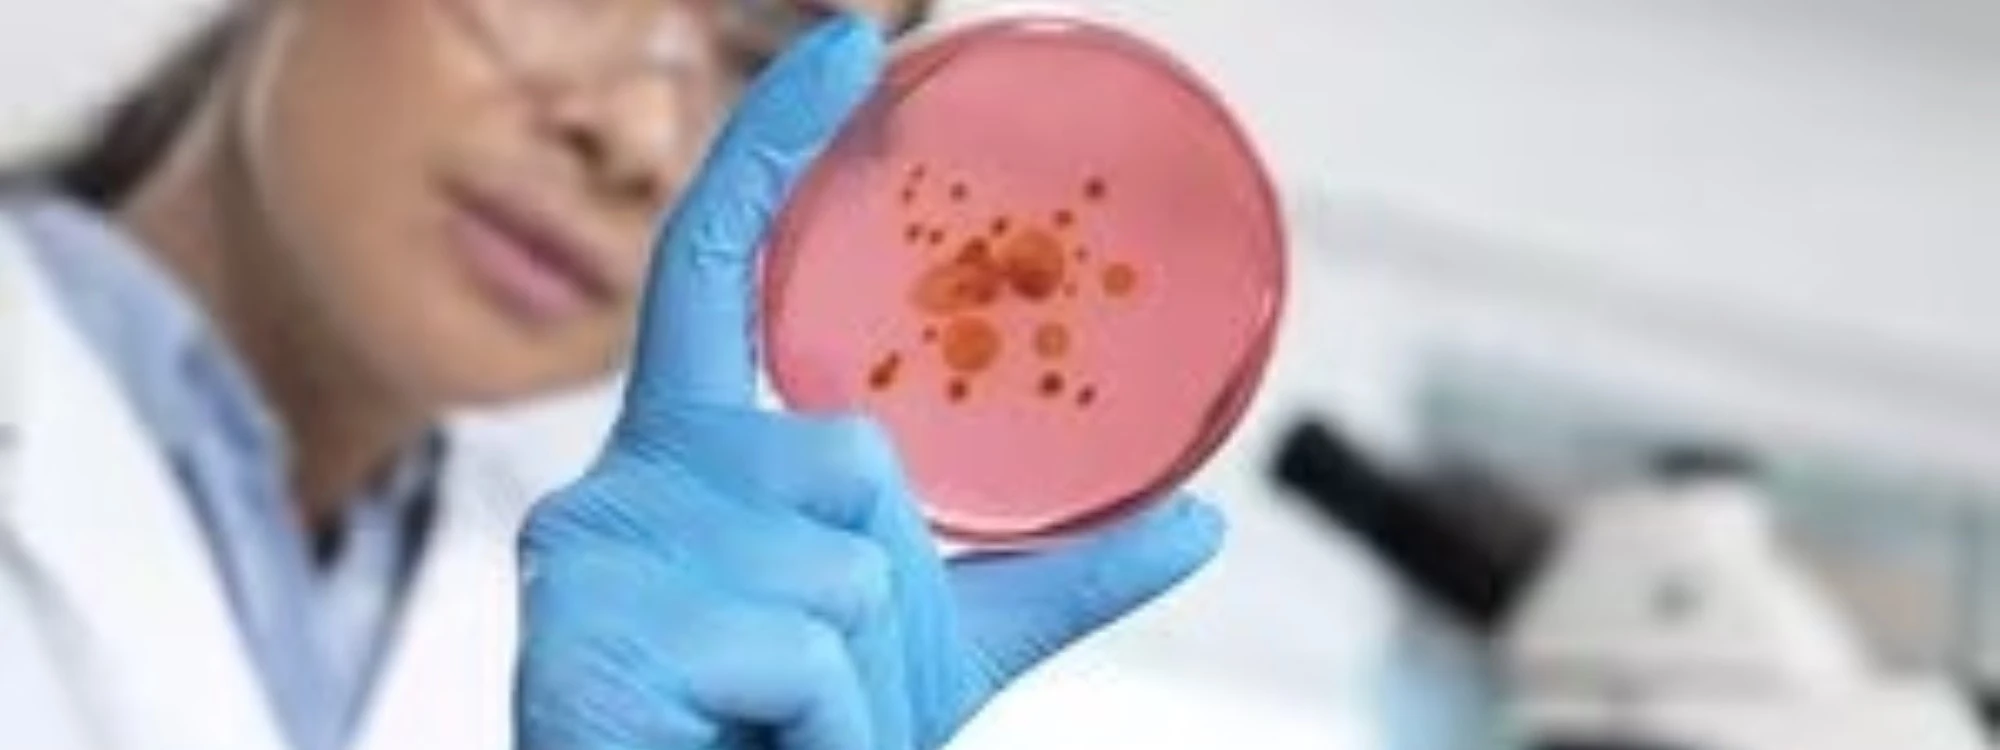
bn2

Experiencia Profesional
Más de 10 años liderando la higiene ocupacional: Tu seguridad en manos expertas.
Tecnología de Vanguardia:
Precisión impulsada por innovación: Evaluaciones avanzadas con tecnología de punta.
Compromiso con la Seguridad y Salud:
Tu bienestar, nuestra prioridad: Garantizamos un entorno laboral seguro.
Certi Lab – Laboratorio de Higiene Ocupacional
Donde la excelencia y resultados confiables se encuentran.
+ de 9 Años
De Experiencia

Nuestros Servicios
Aseguramos una excelencia en nuestros servicios gracias a la pericia y formación de nuestros expertos. Realizamos nuestras labores siguiendo los criterios establecidos en la norma ISO 17025, mediante procedimientos rigurosamente estandarizados y empleando patrones con trazabilidad reconocida por INACAL y organismos internacionales.
Próximo Evento
«PROGRAMA DE ESPECIALIZACIÓN: MONITOREO DE AGENTES OCUPACIONALES»
¿PROMOCIÓN POR PRIMER CURSO DEL AÑO?
- 09-16-23 de Febrero (Presencial o Virtual)
- 10:00 a.m. a 2:00 p.m.
- S/. 350 (Dos participantes por S/. 525)
- Av. xxxxxxxxx, Miraflores, Lima
- Aprende de estas metodologías para reducir el tiempo de evaluación
- Inscripciones:
- +51 955 584 107 / laboratorio@certilab.com









